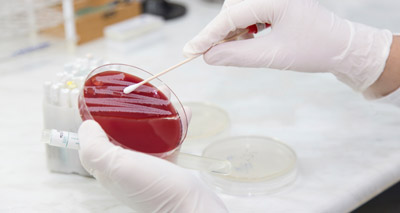

Articles

RVC promotes London as top city for higher education
"It is no surprise to see that London is one of the most popular choices for international students to come...

Final year vet student wins prestigious award
Adeel receiving his award with the vice-chancellor. Adeel Khan scoops Vice Chancellor’s Award after campaign to improve student safety Final...

BVA Northern Ireland elect new president
Simon was elected president after serving a year as a junior vice president. President to be principle representative in relation...
Cell cultures “poor surrogates” for disease
Lab-grown cells used in studies of human disease may not act as a faithful mimic of real tissue. Studies of...

A new era for veterinary communication and professional development
VetCommunity, which is free to join, is at the forefront of a new era of professional veterinary communication. Vision Media...

University to offer research ‘tasters’
Vets will be offered the chance to spend six months doing research in the University of Bristol’s medical labs. Full-time...

